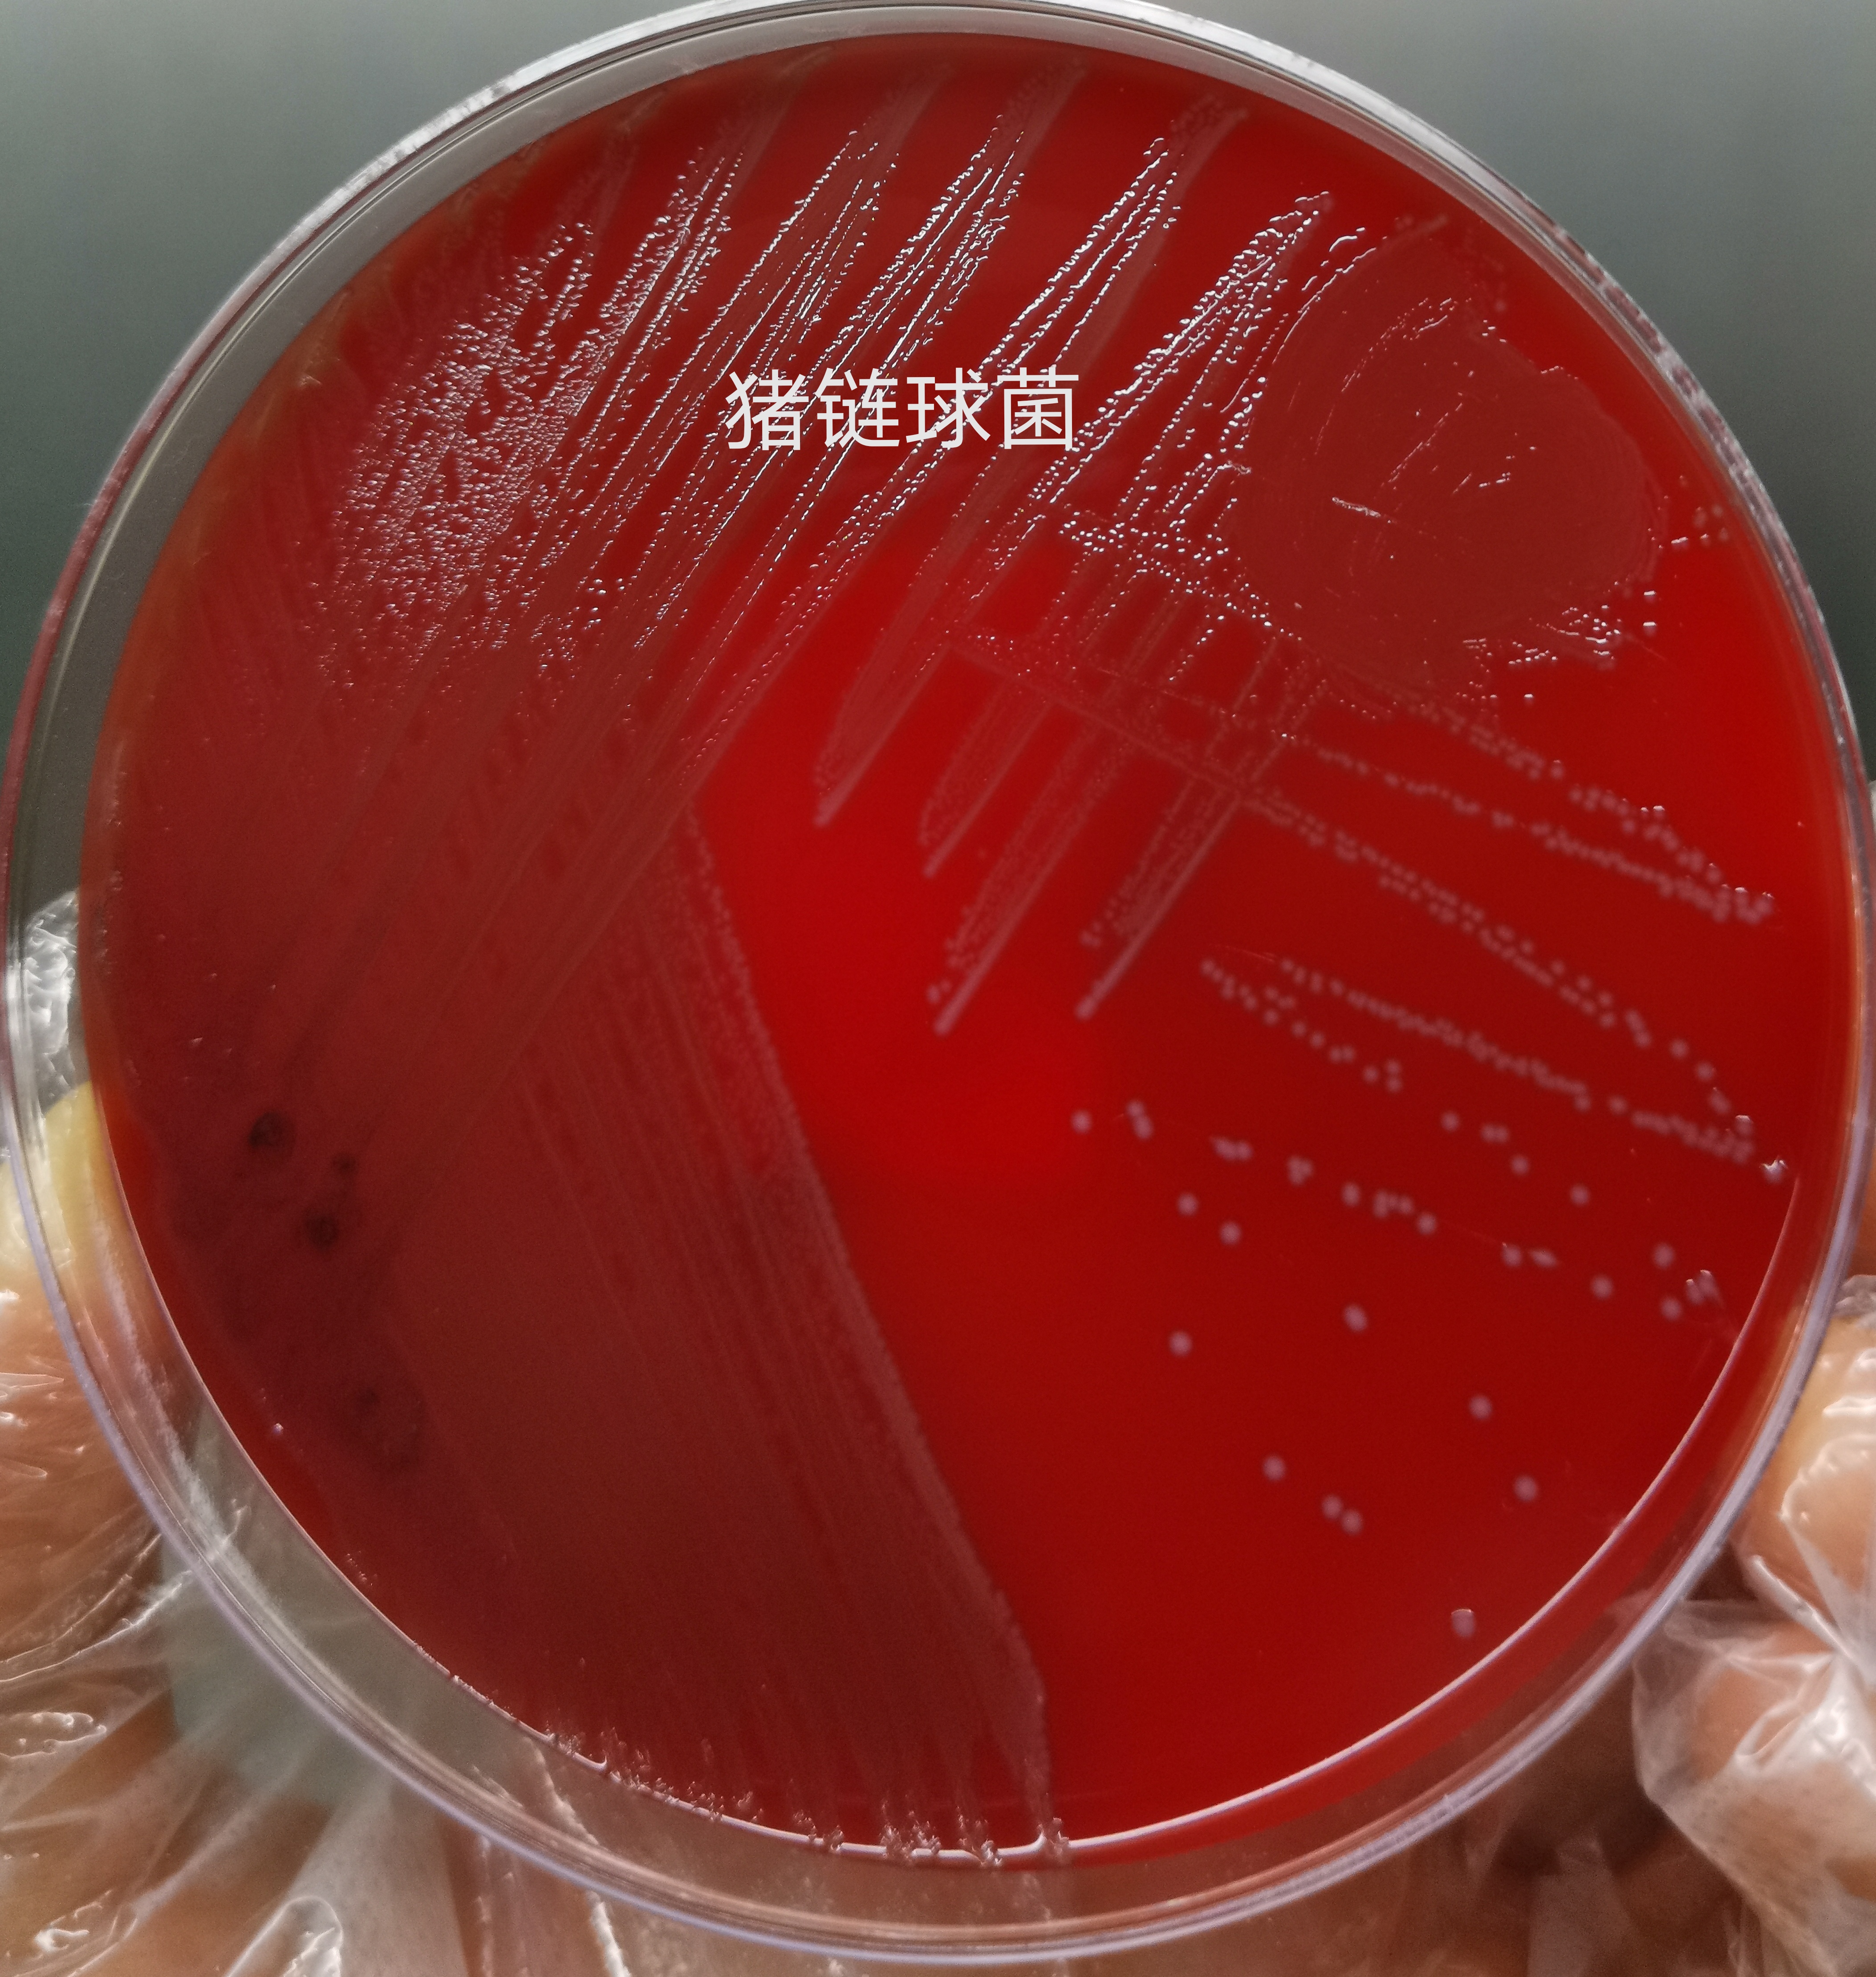
猪肉携带有病菌？感染到人体怎么办？预防措施要做好

新年马上到了,大家都备上年货了吧?忙碌的节日里,餐桌上怎么少得了一道美食!
那就是猪肉

新鲜猪肉
最近碰到了一例比较罕见的感染,和猪有关,是猪链球菌引起的菌血症和脑膜炎。患者是一个屠夫,是因为接触感染的。
1、什么是猪链球菌?
顾名思义,猪链球菌,是因为猪容易感染而得名的。那么它和链球菌属是什么关系?就是凤凰山和山的关系,是链球菌属的一种。这个菌呢分好几种类型,其中 2型 是最厉害的,一般引起人的感染是由2型引起的。人感染猪链球菌病是由猪链球菌经过皮肤黏膜伤口、 呼吸道和消化道感染,主要临床表现为高热、头晕、全身酸痛、乏力纳差,严重者迅速进展为 败血症、中毒性休克综合征或急性化脓性脑膜炎,可危及生命。并非危言耸听,曾经广东汕头就曾报道过此种感染,并且因后遗症险些耳聋!

2、一般什么人容易感染?
病猪和痊愈带菌猪是主要传染源,人群普遍易感,猪的伺养、屠宰、加工、贩运人员及其他接触病死畜者为高危人群,尤其是手部皮肤有破损者,有伤口。猪链球菌传染给人,不是很常见的。吃猪肉呀、杀猪菜还是安全的,大家可以放心吃没有问题。

3、一般猪是怎么感染的呢?
常见有母猪经呼吸道传染仔猪,初生仔猪因脐带伤口感染等,其次是食入或接触被细菌污染的饲料,水后经消化道感染。在猪中发病率和病死率可达30%左右。
4、猪链球菌长什么样子?
首先,我们将感染人的脑脊液、血液直接进行了涂片染色,我们在显微镜下直接就发现了细菌.大家能看到紫色的小颗粒吗?放大镜下就是此菌,在血管里,脑袋里都有!

猪链球菌
然后我们将感染者血和脑脊液培养了一下,培养基上长了一层东西,这样我们就分离出了猪链球菌,24~48h的培养后可见不同溶血的菌落!
灰白色细小菌落
将小菌落重新涂片,再放到显微镜下,看到了这个样子

紫色的球菌,成对成链排列,这就是猪链球菌!
5、这个应该怎么预防,怎么治疗呢?

猪链球菌感染,可以通过我们的试验,筛选出敏感的抗生素进行治疗。
对于小猪猪,我们是有疫苗可以注射的,也可以通过抗生素进行治疗。其实这些年,我们人类作为食物链的最顶端,体内有些耐药菌的出现,也和畜牧业应用抗生素有关的。百姓口中的消炎药就是抗生素。所以规范抗生素的使用,还是十分必要的,
还有就是对于人感染猪链球菌病,大众也无需太恐慌,并不是所有的猪肉都携有猪链球菌,也不是接触猪肉就会感染。建议做菜时要煮熟煮透,同一菜板不要又切生肉又切熟肉,降低交叉感染风险。